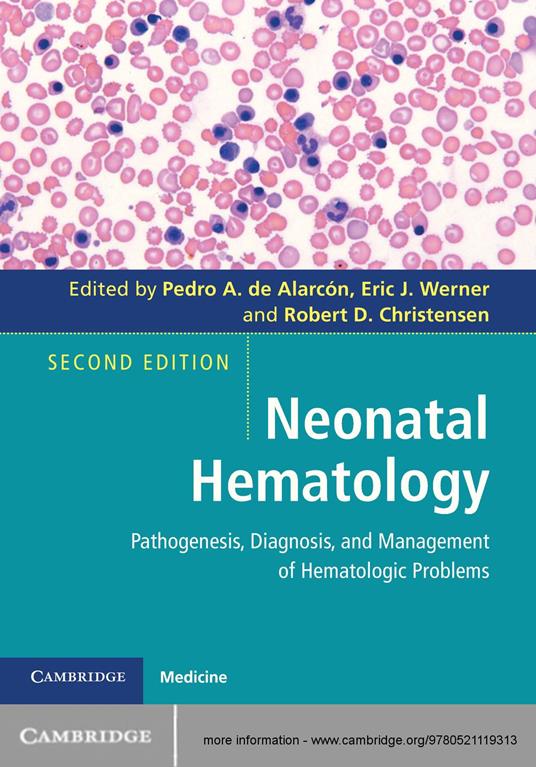
Neonatal Hematology

Neonatal Hematology
Neonatal hematology is a fast-growing field, and hematologic problems occur in the majority of sick neonates. Focusing on clinical issues and problem-solving, this is a fully revised and updated revision of a successful practical guide to the pathogenesis, recognition and management of hematologic problems in the neonate. The second edition begins with chapters on the history of neonatal hematology, hematopoiesis, and the immunologic system. Subsequent sections are devoted to erythrocyte disorders, platelet disorders, leucocyte disorders, immunologic disorders and hemostatic disorders. New to this edition are an expanded coverage of neonatal oncology, cord blood utilization, neonatal screening, prenatal diagnosis and hyperbilirubinemia. Written by practising physicians specializing in pediatric hematology, neonatology, immunology, pediatric infectious disease and transfusion medicine, this is an essential text for pediatric hematologists, NICU specialists, neonatologists and neonatal nurse practitioners.
-
Curatore:
-
Anno edizione:2015
-
Editore:
-
Formato:
Formato:
Gli eBook venduti da Feltrinelli.it sono in formato ePub e possono essere protetti da Adobe DRM. In caso di download di un file protetto da DRM si otterrà un file in formato .acs, (Adobe Content Server Message), che dovrà essere aperto tramite Adobe Digital Editions e autorizzato tramite un account Adobe, prima di poter essere letto su pc o trasferito su dispositivi compatibili.
Cloud:
Gli eBook venduti da Feltrinelli.it sono sincronizzati automaticamente su tutti i client di lettura Kobo successivamente all’acquisto. Grazie al Cloud Kobo i progressi di lettura, le note, le evidenziazioni vengono salvati e sincronizzati automaticamente su tutti i dispositivi e le APP di lettura Kobo utilizzati per la lettura.
Clicca qui per sapere come scaricare gli ebook utilizzando un pc con sistema operativo Windows